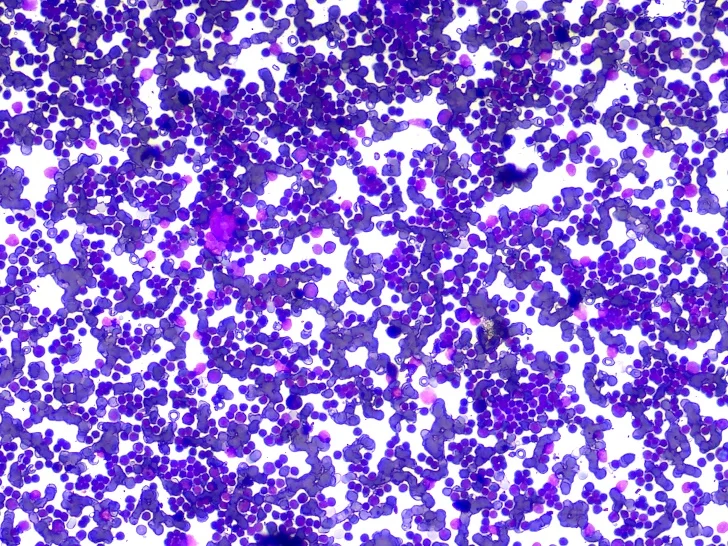
thumb

BestScope BUC2D-1200C 12MUSB2.0 Graphics Accelerated Microscope Camera for Trinocular Microscope
Price history chart & currency exchange rate
Customers also viewed

$34.00
Вентилятор охлаждения ЦП для ноутбука CLEVO N151RD N151RF N151RF1 N151RF1-G N151SC N151SD, черный
aliexpress.com
$60.48
SWANEE 4x4 HD кружевная застежка афро странные вьетнамские волосы Remy человеческие волосы прозрачные кружевные предварительно выщипанные натуральные волосы для женщин
aliexpress.com
$260.28
High Chair Bar Bancos Height Stools Luxury Kitchen Stool Barbershop Lightweight Chairs Nordic Taburetes Altos Beauty Salon
aliexpress.com
$13.94
S925 Стерлинговое Серебро, 30 популярных стилей, кольца, ожерелья, подвески, классические, простые и щедрые серьги оптом
aliexpress.ru
$60.04
Мотоциклетные MX подножки для внедорожника, широкие напольные подножки, педали для Sportster XL 1200 883 Dyna FXDF Softail
aliexpress.ru
$114.53
Комфортные уличные пляжные стулья, складные сверхлегкие пляжные стулья для пикника, кемпинга, портативные складные садовые стулья для пикника QF50BC
aliexpress.ru
$9.98
Vintage Medieval Headband with Bangle&Sunglasses Delicate Ball Earring&Necklace Set Festival Party Ladies Props XXFD
aliexpress.com
$13.75
GTBL 8X Aluminum Alloy Security Automatic Window Gate Lock Spring Bounce Door Bolt Latch, Black
aliexpress.com
$10.79
2022 для HONDA CBR650R CBR 650R 2019 2020 2021, решетка радиатора мотоцикла, защитная крышка CBR650 R, аксессуары для мотоцикла
aliexpress.ru
$6.86
ChainX Crypto Color Changing Mug in the Sky Graphic Ceramic Heat-sensitive Cup Novelty Eth Tea cups
aliexpress.ru
$2.98
2018 Hot summer sweet girls lace flower princess dress fashion beach cowboy sleeveless chiffon mini skirt.
aliexpress.com
$3.38
Путешествие по Сказочной России. Путеводитель для всей семьи. Специальное предложение
bookvoed.ru
$104.58
designer womens shoulder bags bags luxury tote bag genuine leather hers gold silver buckle handbag crossbody messager cosmetic purses wallet
dhgate.com
$18.78
925 sterling silver charms open bracelet heart tbar sparkling snake bangle beads original fit pandora bracelet jewelry making diy6829051, Black
dhgate.com
$68.95
gagarich women new jumpsuits v-neck trumpet short sleeves waist lace chiffon printed beach style ladies cool playsuit t200704, Black;white
dhgate.com
$420.46
magic cool skin cooler device for beautician use cryo cool electroporation no needle mesotherapy skin face lifting machine7248141
dhgate.com
$142.66
designer bags birkins h handbags handbag 2023 new fashion leisure womens platinum large capacity one shoulder messenger bag
dhgate.com
$80.45
Car Front Fog Light Lamp Cover Grille Trim for BMW- X3 G01 G08 X4 G02 2018 2019 2020 2021 (Without Fog Lamp Hole)
aliexpress.com
$8.34
Makeup Organizer For Cosmetic Large Capacity Cosmetic Storage Box Jewelry Nail Polish Makeup Multi-Layer Desktop Storage Rack
aliexpress.com
$2.88
Space Surfing Polyester Pillow Cover Decorative Pillows for Sofa Bedroom Pillow Cases Home Decor Cushion Covers 45*45cm
aliexpress.com
$1.73
12Pcs Pain Relief Patch Shoulder Knee Neck Back Stickers Arthritis Joint Chinese Herbal Medical Plaster
aliexpress.com
$6.06
Adjustable Skiing Pole Shoulder Carrier Straps with Protector Loop Handhold Adhesive Snowboard Fixing Strap Outdoor Skiing Tools
aliexpress.com
$3.63
Screw Eye Pin Key Chain Key Ring keychain Bronze Rhodium Gold Keyrings Split Rings With Screw Pin Jewelry Making
aliexpress.com
$22.49
6Pcs Simulation Electric Mini Household Children Play House Kitchen Washing Machine Juier Toy Gift
buyincoins.com
$38.80
Тонкий регулируемый во французском ретро-стиле с открытой спиной топ-труба для груди тонкий кружевной антибликовый жилет
aliexpress.com
$23.04
Women's Harem Pants Sports Sweatpants Women's Tracksuit Oversize Joggers Embroidery Harajuku Korean Fashion Trousers for Female
aliexpress.com
$10.51
Py21w Led Canbus 1156 BAU15S 7507 Parking Turn Signals Lights Bulbs On Car Tail Diode Lamps For Auto W21W 7443 P21w 3157 T20 T25
aliexpress.com
$20.15
Casual brand hooded plaid shirt men's shirt long sleeve 2020 new autumn cotton fabric plaid jacket Asian size M-5XL
aliexpress.com